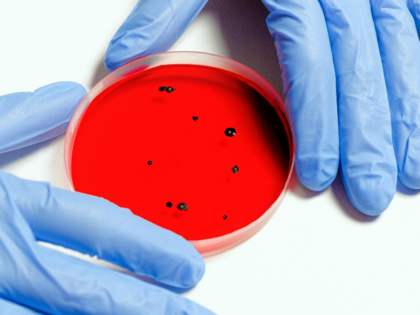
Scientist Holding Petri Dish

Researchers: Chemical Used in Dry Cleaning Linked to Significant Risk of Liver Fibrosis
Researchers have found exposure to a common chemical used in dry cleaning, some adhesives, spot cleaners, and stainless steel polish, may be linked to a liver disease.